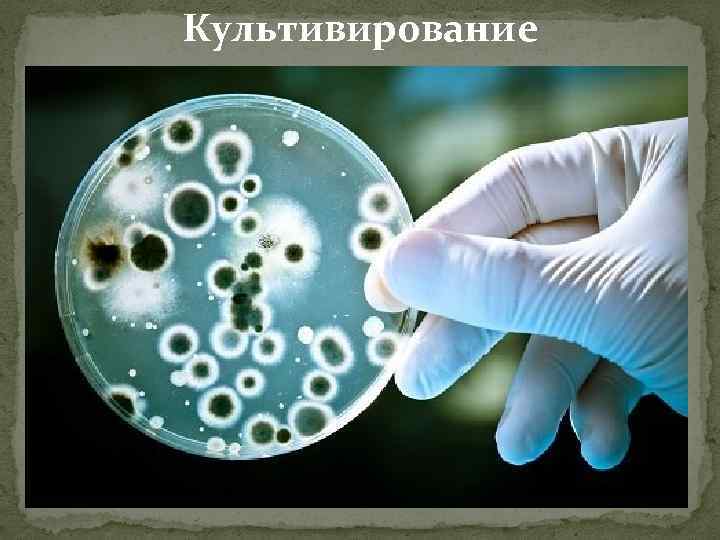
Культивирование

Prezentatsia1.pptx
- Количество слайдов: 20

Обследование пациентов с заболеваниями пародонта Сделано: Студенткой 4 курса 10 группы Колесниковой Алёной Андреевной

Методы диагностики можно классифицировать на: - Клинические - Рентгенологические - Лабораторные - Функциональные

Клинические методы




Рентгенологические методы

Ортопантомограмма

Компьютерная томография

Прицельный снимок

Методы лабораторной диагностики можно систематизировать следующим образом: - микробиологические - иммунологические - биохимические - цитологические

микробиологические: - микроскопирование - культивирование - метод полуколичественной оценки роста анаэробной и аэробной микрофлоры - исследование на дисбактериоз - определение чувствительности микроорганизмов к антибиотикам

Микроскопирование
Культивирование

Функциональные методы исследования: - реопародонтография - лазерная доплеровская флоуметрия - ультразвуковая высокочастотная допплерография - эхоостеометрия

Реография

Лазерная доплеровская флоуметрия

Ультразвуковая высокочастотная доплерография

Эхоостеометрия

Спасибо за внимание
Prezentatsia1.pptx